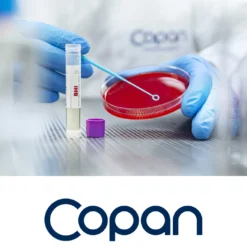
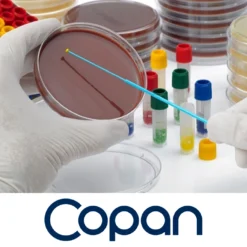
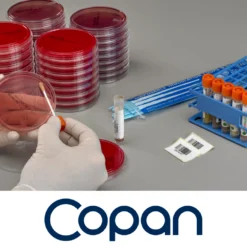

Laboratorío clínico
Inocuidad Alimentaria
Laboratorío clínico
Laboratorío clínico
Laboratorío clínico
Laboratorío clínico
Laboratorío clínico
Laboratorío clínico
Laboratorío clínico
Laboratorío clínico
Laboratorío clínico
Laboratorío clínico
Inocuidad Alimentaria
Laboratorío clínico
Laboratorío clínico
Laboratorío clínico
Laboratorío clínico
Análisis de orina
Laboratorío clínico